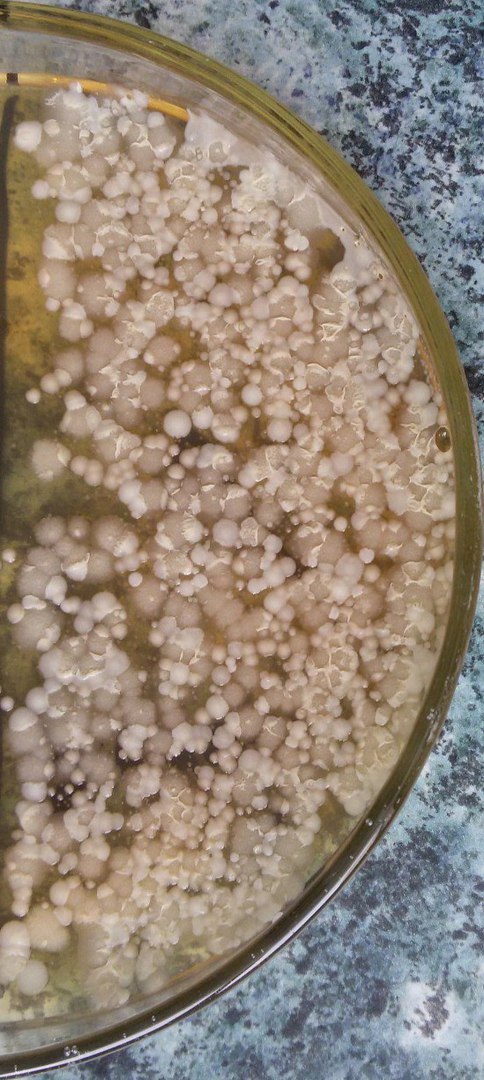

Make a Submission
ISSN
![]() Online 2414-9985
Online 2414-9985
![]() Print 2413-6077
Print 2413-6077
Information
All materials are published under the Creative Commons Attribution (CC BY) licence.
Submission of a manuscript implies the author’s agreement with these terms. The author confirms that the work is original, does not infringe third-party rights, and has not been published elsewhere.
The author retains copyright, while the publisher holds the right of first publication and distribution in print and electronic form, including authorised English translation.
Any use of the article must include a citation or hyperlink to the publication on the journal’s website.